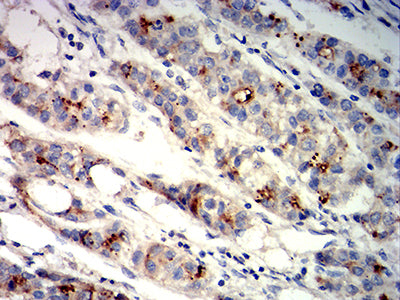

Mouse Monoclonal Antibody to GPC3
Description |
|---|
Cell surface heparan sulfate proteoglycans are composed of a membrane-associated protein core substituted with a variable number of heparan sulfate chains. Members of the glypican-related integral membrane proteoglycan family (GRIPS) contain a core protein anchored to the cytoplasmic membrane via a glycosyl phosphatidylinositol linkage. These proteins may play a role in the control of cell division and growth regulation. The protein encoded by this gene can bind to and inhibit the dipeptidyl peptidase activity of CD26, and it can induce apoptosis in certain cell types. Deletion mutations in this gene are associated with Simpson-Golabi-Behmel syndrome, also known as Simpson dysmorphia syndrome. Alternative splicing results in multiple transcript variants. |
References |
|---|
| 1.J Cancer Res Clin Oncol. 2018 Dec;144(12):2399-2418. 2.Medicine (Baltimore). 2018 Jun;97(24):e11130. |
Specification |
|
|---|---|
| Aliases | SGB; DGSX; MXR7; SDYS; SGBS; OCI-5; SGBS1; GTR2-2 |
| Entrez GeneID | 2719 |
| Swissprot | P51654 |
| clone | 2C7E9 |
| WB Predicted band size | 65.5kDa |
| Host/Isotype | Mouse IgG1 |
| Antibody Type | Primary antibody |
| Storage | Store at 4°C short term. Aliquot and store at -20°C long term. Avoid freeze/thaw cycles. |
| Species Reactivity | Human |
| Immunogen | Purified recombinant fragment of human GPC3 (AA: 359-554) expressed in E. Coli. |
| Formulation | Purified antibody in PBS with 0.05% sodium azide |
Application |
|
|---|---|
| WB | 1/500 - 1/2000 |
| IHC | 1/200-1/1000 |
| FCM | 1/200-1/400 |
| ELISA | 1/10000 |
Product Image
-
Black line: Control Antigen (100 ng);Purple line: Antigen (10ng); Blue line: Antigen (50 ng); Red line: Antigen (100 ng)

-
Western blot analysis using GPC3 mouse mAb against HEK293 (1) cell lysate.

-
Flow cytometric analysis of Hela cells using GPC3 mouse mAb (green) and negative control (red).

-
Flow cytometric analysis of HepG2 cells using GPC3 mouse mAb (green) and negative control (red).

-
Immunohistochemical analysis of paraffin-embedded human liver cancer tissues using GPC3 mouse mAb with DAB staining.

鄂公网安备42018502007531号
鄂公网安备42018502007531号

